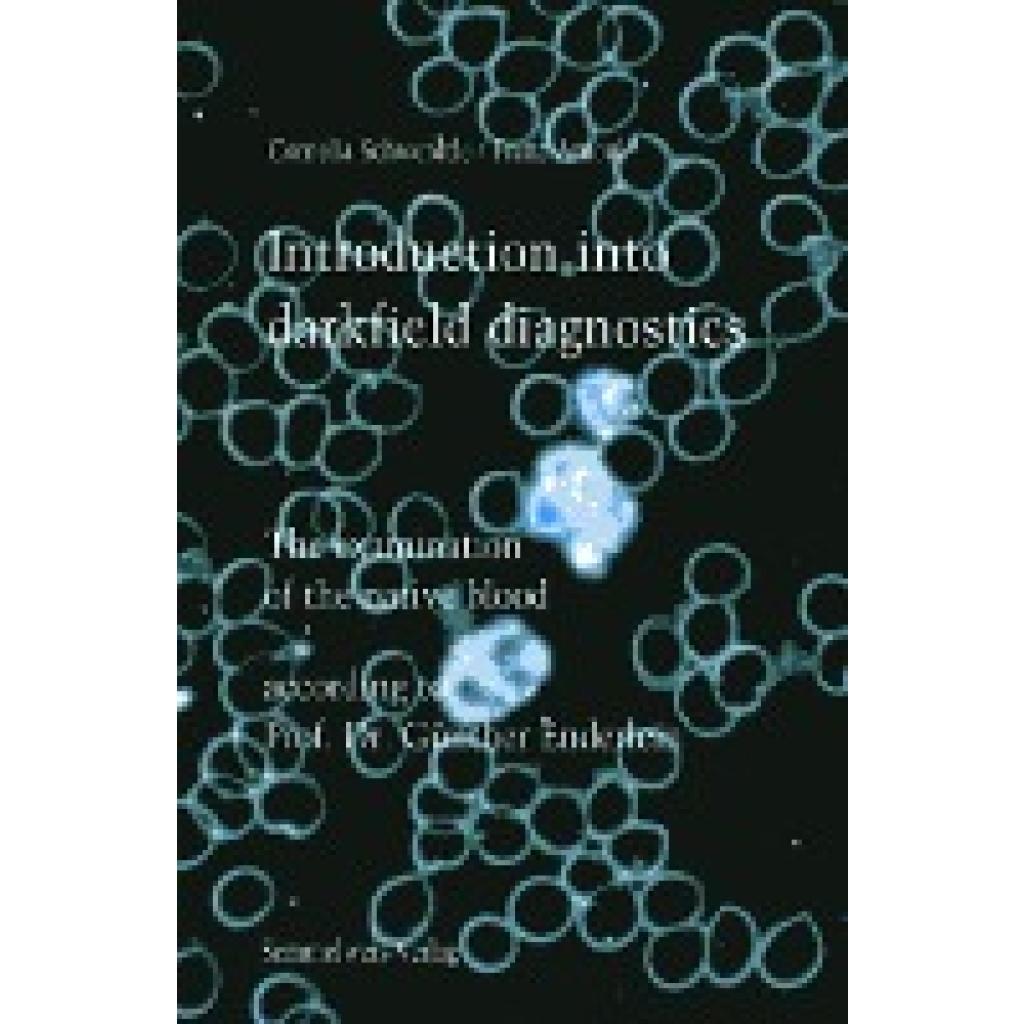

Beschreibung
The examination of native blood according to Prof. Dr. Günther Enderlein
| EAN: | 9783925524479 |
| Farbverschnitt: | Generell werden die Bücher ohne Farbverschnitt geliefert, auch wenn die Abbildungen einen Farbverschnitt zeigen. |
| Auflage: | 2., Aufl., 06002 |
| Erscheinungsjahr: | 2006 |
| Produktform: | Leinen, Gebunden |
| Autoren: | Arnoul, Franz & Schwerdtle, Cornelia |
| Edition: | REV |
| Auflage/Ausgabe: | 2., Aufl |
| Seitenzahl/Blattzahl: | 163 |
| Abbildungen: | zahlreiche Schwarz-Weiß- und farbige Abbildungen |
| Keyword: | Blood examination; Dark field microscopy; Diagnostic |
| Fachkategorie: | Alternativmedizin |
| Thema: | Verstehen |
| Text Sprache: | eng |
| Verlag: | Semmelweis-Institut, Semmelweis-Institut Verlag fr experimentelle Onkologie GmbH |
| Länge: | 224 mm |
| Breite: | 157 mm |
| Höhe: | 17 mm |
| Gewicht: | 473 gr |
| Genre: | Mathematik/Naturwissenschaften/Technik/Medizin |
| Herkunftsland: | DEUTSCHLAND (DE) |